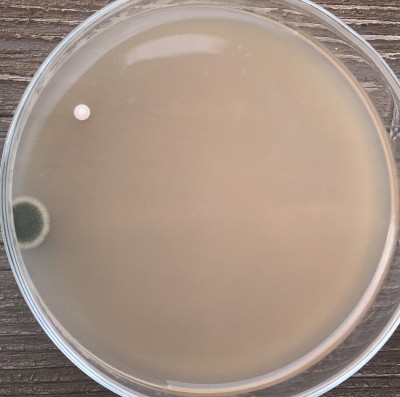
1h_Labor_nach_6_Tagen.jpg (801.51 KiB) 11692 mal betrachtet Konti Arbeitsecke
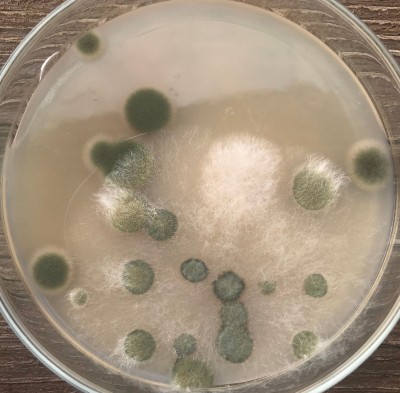
1h_Balkon_nach_6_Tagen.jpg (990.74 KiB) 12014 mal betrachtet Konti Balkon

Seite 1 von 1
Test Keimbelastung Arbeitsecke vs. Balkon
Verfasst: Samstag, 23. Juni 2018 15:16
von GrafDracula
Ich hab neulich mal 2 frisch sterilisierte Petri's (45min im normalem DDKT bei schätzungsweise ca. 117°C) zum Test jeweils 1h offen auf'm Balkon und die andere 1h lang offen in meiner Arbeitsecke rum stehen lassen, weil ich einfach mal sehen wollte, wie unterschiedlich die Keimbelastung ist. Ist übrigens ganz normales Malz-Agar. 10 weitere frisch sterilisierte Petri's aus dem gleichen Schwung, die ich auf Vorrat produziert und im gleichen Raum gelagert habe, sind zu 100% ohne eine einzige Konti. Dass die Kontamination in den beiden Petri's aus unzureichender Sterilisation kommt, kann man also ausschließen.
Hier das Ergebnis nach 6 tägigem Wachstum bei 22°C:
Arbeitsecke:

- Konti Arbeitsecke
Balkon:
- Konti Balkon
Es schwirrt zwar was rum in der Arbeitsecke, was ich definitiv nicht in den Körnerbruten, oder auf ner Petri haben will, aber es ist schon mal nicht sooooooo schlimm, außerdem arbeite ich ja zusätzlich noch inner GloveBox, wenn man da also dann mal kurz den Deckel öffnet, oder wie hier mal angemerkt durch rausziehen der Hände Luft durch den Deckel nachgezogen wird, ist die Chance, dass da gleich ne Konti mit dabei ist, relativ gering ... aber definitiv nicht auszuschließen. Für die Hobbyzucht reicht das auf jeden Fall ...
Re: Test Keimbelastung Arbeitsecke vs. Balkon
Verfasst: Samstag, 23. Juni 2018 19:52
von Ständerpilz
Wundert mich, dass auf der Balkon-Platte nicht viel mehr gewachsen ist. Die Arbeitsecke sieht doch gut aus. Nur 2 Keime, obwohl sie 1 h lang offen herum stand - das ist nicht schlecht!
Re: Test Keimbelastung Arbeitsecke vs. Balkon
Verfasst: Sonntag, 24. Juni 2018 09:33
von GrafDracula
Ja, spontan aus dem Bauch heraus hätte ich auf'm Balkon auch mehr vermutet, zumal auch gut Wind war ... aber das wichtigere ist die Arbeitsecke, der Balkon war ja nur zum Vergleich.
Re: Test Keimbelastung Arbeitsecke vs. Balkon
Verfasst: Sonntag, 24. Juni 2018 11:57
von ohkw
Also mit dem Keimniederschlag in der Arbeitsecke kann man wirklich leben. Da dürfte bei normaler Arbeitsweise mit den Platten kaum je eine Konti dabei sein.
Ich bleibe nach wie vor dabei, dass die Glovebox mehr stört als nützt, weil unhandlich usw. Für normale arbeiten jedenfalls.
Wenn du so Dinge machen willst, wie über offenen Platten eine Morchel aufhängen damit die Sporen runterfallen ist so eine Box sicher hilfreich.
Im Morchelthread hattest du btw. ja auch jede Menge Kondenswasser in den Platten. Gießt du steril oder sterilisierst du nachträglich? Bei letzterem ist das mit dem Kondenswasser praktisch immer eine Katastrophe, bei ersterem hilft es die Agarmischung vor dem Gießen etwas Abkühlen zu lassen.
Re: Test Keimbelastung Arbeitsecke vs. Balkon
Verfasst: Sonntag, 24. Juni 2018 13:35
von GrafDracula
ohkw hat geschrieben:Gießt du steril oder sterilisierst du nachträglich? Bei letzterem ist das mit dem Kondenswasser praktisch immer eine Katastrophe ...
Ja, ich gieße erst und sterilisieren dann im DDKT, daher das ganze Kondenswasser. Bis auf dass es beim Fotografieren stört, hab ich bis jetzt aber noch keinen Nachteil bemerkt ... ich hab auch schon versucht langsam abzukühlen, den DDKT in ne dicke Decke einzupacken beim Abkühlen ... nix hilft. Wachsen tut das Myzel trotzdem einwandfrei und wenn keine Kontis drin sind, kann das Kondenswasser ja auch nicht rumgammeln

Re: Test Keimbelastung Arbeitsecke vs. Balkon
Verfasst: Montag, 25. Juni 2018 19:02
von Ständerpilz
GrafDracula hat geschrieben:ohkw hat geschrieben:Gießt du steril oder sterilisierst du nachträglich? Bei letzterem ist das mit dem Kondenswasser praktisch immer eine Katastrophe ...
Ja, ich gieße erst und sterilisieren dann im DDKT, daher das ganze Kondenswasser. Bis auf dass es beim Fotografieren stört, hab ich bis jetzt aber noch keinen Nachteil bemerkt ... ich hab auch schon versucht langsam abzukühlen, den DDKT in ne dicke Decke einzupacken beim Abkühlen ... nix hilft. Wachsen tut das Myzel trotzdem einwandfrei und wenn keine Kontis drin sind, kann das Kondenswasser ja auch nicht rumgammeln

Ich sehe das so wie ohkw und bin kein Fan von Glove boxes. Allerdings würde so eine Petrischale meist vermutlich ganz anders aussehen, nämlich wesentlich kontaminierter. Wahrscheinlich war es gerade ziemlich windstill und es gab keine Luftbewegung. Normalerweise liegt überall ein klein wenig Staub, der aufwirbelt, sobald jemand vorbei geht. oder eben durch den Wind bzw Durchzug.
Zum Kondenswasser in Glaspetris: Doch, das kriegt man weg bzw kann dafür sorgen, dass es sich gar nicht erst bildet. Das Kondenswasser bildet sich am Deckel, weil der Wasserdampf vom heißen Agar am relativ kalten Deckel kondensiert. Wenn der Deckel warm genug ist, dann kondensiert da folglich auch nichts. Man könnte auf frisch gegossene Petris mit Deckel eine Styroporplatte legen, die isoliert und dadurch verhindert, dass der Deckel zu sehr abkühlt.
Ich persönlich bevorzuge Plastik-Petrischalen und gieße die steril (neben Brennerflamme). Dabei stapele ich die gegossenen Petris übereinander und die oberste decke ich mit einer Styroporplatte ab und beschwere diese, damit sie nicht runter fällt. Wenn sie vollständig abgekühlt sind, verschließe ich die Petris einzeln mit Parafilm und stecke sie dann in den Beutel zurück. Oder ich verbrauche sie sofort.